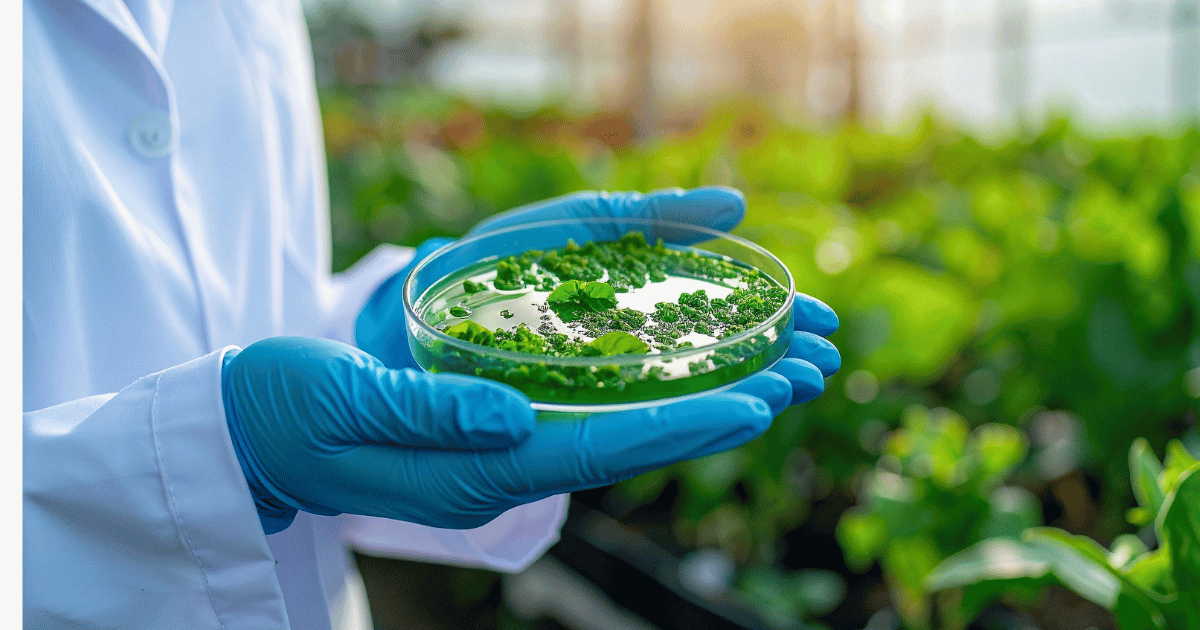

Karya Lingkar Hijau (KLH) is a community enterprise pioneering biotech innovation in algae and
seaweed, driving sustainable solutions for carbon capture, aquaculture, and high-value bioproducts.
By integrating science, sustainability, and social empowerment, KLH develops advanced bioreactors and
cultivation techniques to optimize seaweed and microalgae growth, transforming aquaculture waste into
valuable bioresources. Collaborating with coastal communities, researchers, and industry partners,
KLH not only restores marine ecosystems but also empowers women, youth, and small-scale farmers through
training, technology access, and market integration. Our mission is to build a circular bioeconomy ecosystem,
harnessing the power of algae for environmental restoration, climate action, and economic resilience, bridging
the gap between innovation and sustainability for a better future.